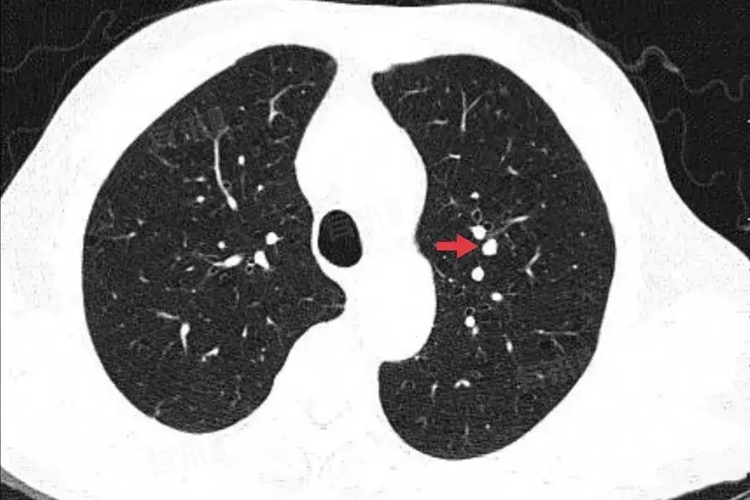

右下肺小结节是相对常见的影像学描述,指的是在通过胸部X线、CT等影像学检查时,发现的位于右肺下叶的、直径小于或等于3厘米的类圆形或不规则形病灶,其密度高于周围正常肺组织。这些小结节的边界可以是清晰的,也可能较为模糊,在影像学图像上呈现出与周围肺实质密度不同的阴影。
- 从成因来看,右下肺小结节的形成涉及多种因素。感染因素是较为常见的原因之一,例如结核菌感染后,肺部可能会出现以肉芽肿性病变为主的小结节。结核菌在肺部引发免疫反应,大量免疫细胞聚集,形成结核结节,经过影像学检查就表现为小结节影。
- 细菌、真菌等病原体感染也可能导致类似情况,细菌感染引发的炎症在愈合过程中,可能会残留一些纤维组织增生,进而形成小结节。真菌在适宜的肺部环境中生长繁殖,也能刺激肺部组织产生炎性反应,最终发展为小结节。
- 肺部的良性肿瘤同样可能表现为右下肺小结节,错构瘤是肺部常见的良性肿瘤,它由肺部正常组织的异常组合构成,包含软骨、脂肪、平滑肌等成分。错构瘤生长缓慢,通常在体检时偶然被发现,呈现为边界清晰、密度不均匀的小结节。肺纤维瘤也是良性肿瘤的一种,由纤维组织构成,其形成可能与肺部局部的纤维组织异常增生有关,在影像学上多表现为密度均匀、边缘规则的小结节。
- 肺癌是导致肺部小结节的严重病因,尤其是在长期吸烟、有肺癌家族史等高危人群中。早期肺癌如原位腺癌、微浸润腺癌,可能仅表现为右下肺的小结节。这些小结节在影像学上可能具有恶性特征,如分叶征、毛刺征、胸膜牵拉征等。
分叶征指结节边缘呈凹凸不平的多个弧形,形似花瓣;毛刺征表现为结节边缘向周围伸展的细短毛刺;胸膜牵拉征则是结节与胸膜之间存在条索状影相连,这些特征提示结节的生长方式具有侵袭性,需高度警惕。
右下肺小结节的注意事项
1、关注身体异常症状:高危人群要密切留意自身身体变化,若出现咳嗽、咯血、胸痛、气短、发热、体重下降等症状,不要忽视,应及时就医。详细向医生描述症状出现时间、频率、程度及伴随症状,以便医生准确判断,进行针对性检查,排查右下肺小结节及其他肺部疾病。如出现不明原因的持续咳嗽,且伴有少量咯血,应尽快前往医院呼吸内科就诊。
2、配合检查与评估:在进行肺部检查时,高危人群要积极配合医生各项检查与询问。如实告知医生吸烟史、职业接触史、家族病史、既往疾病史等信息,不要隐瞒或遗漏重要细节。对于医生安排的检查,如痰液细胞学检查、支气管镜检查、经皮肺穿刺活检等,要认真完成,确保检查结果准确可靠,为医生诊断提供全面信息,早期明确右下肺小结节性质。

